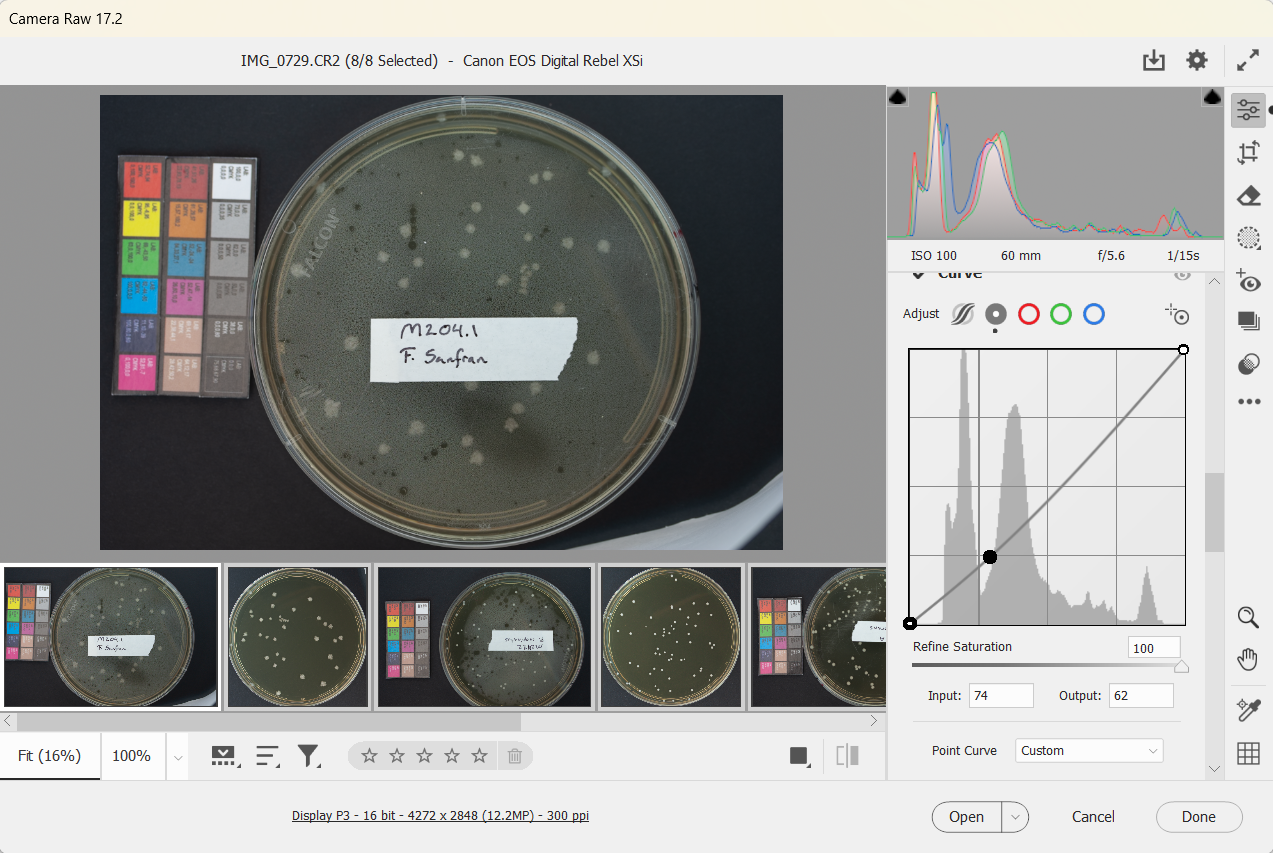
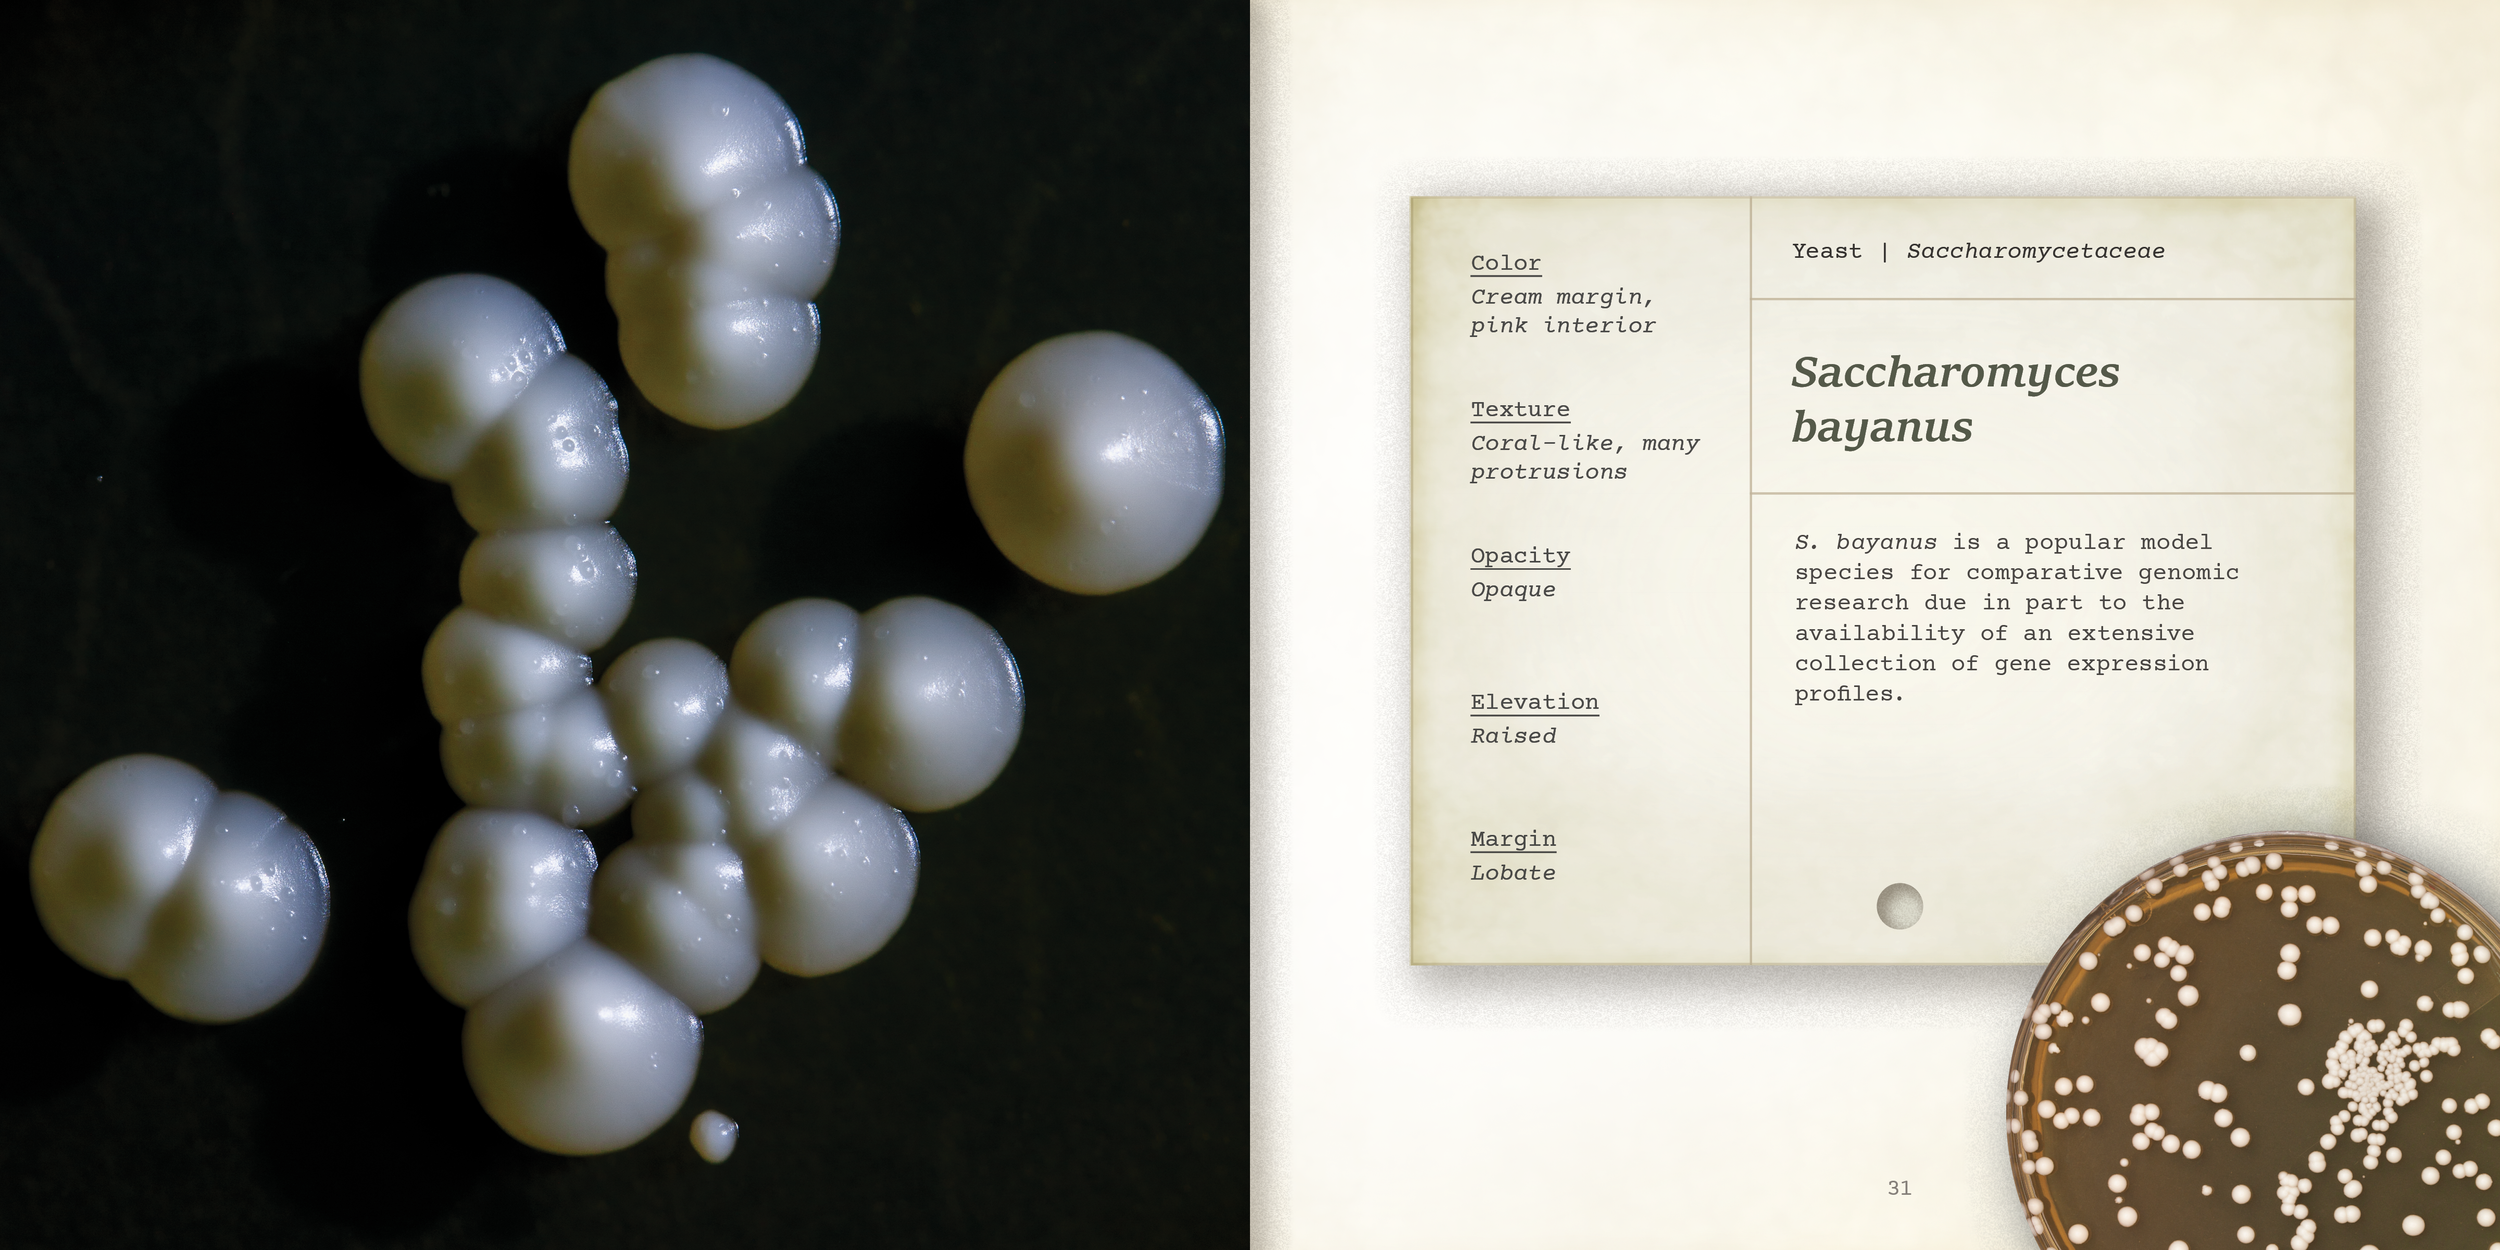
new vintage fieldguide card - smaller card.png

The Field Guide to Sourdough Microbes
At my internship at the Oliverio Lab, we are crafting a fully illustrated coffee table book that would allow bakers and home microbiologists a non-perishable way to flaunt their love for sourdough, an ancient food stable whose cultivation has been passed down for generations.
Our aesthetic vision is rooted in the scientific illustration tradition. All text is written by Cammie Murray.
Illustrating concepts in microbiology and ecology
The first section of our book will explain the science our lab is conducting, and how sourdough helps us answer deep questions in microbiology, ecology, and beyond.
My illustrations are crafted to make these topics both visually appealing and conceptually clear.












Revealing the intricate details of familiar microbes

Lately, our book features a field guide to sourdough microbes, containing beautiful photographs to reveal intricate details of the microbes that have fed us for generations.
Baked with love
This project would not be possible without my expertise in the Adobe Suite. InDesign, Illustrator, and Photoshop were all my weapons of choice.